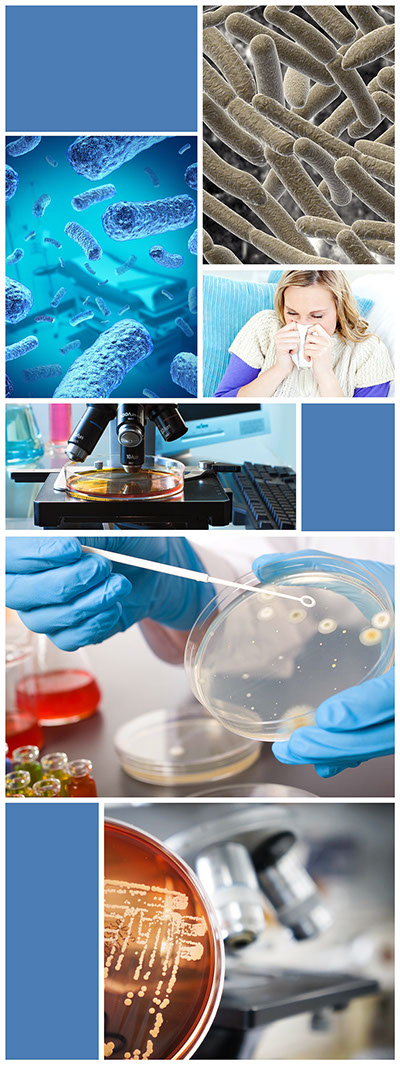

Infektiologie
Die Infektiologie der Atemwege ist eine Domäne der Hals-Nasen-Ohrenheilkunde. Durch HNO-typische Untersuchungstechniken wie endoskopische Untersuchungen der Atemwege, Ultraschall der Nasennebenhöhlen, Ultraschall des Halses können Infekte und deren Komplikationen präzise und schnell diagnostiziert und zielsicher behandelt werden. Durch ergänzende Labor-Analysen wie bakteriologische Abstriche und Blutwerte kann mit grosser Genauigkeit zwischen viralen und bakteriellen Infekten unterschieden werden und auch seltene, atypische Infektionserreger nachgewiesen werden. Hierdurch kann die Gabe von Antibiotika auf die unbedingt erforderlichen Fälle beschränkt werden und, falls erforderlich, eine zielgerichtete Wirkstoffauswahl erfolgen. Hierbei hilft z.B. auch die Bestimmung des C-reaktiven Proteins (CRP), einem Entzündungsparameter im Blut, den wir in unserem praxiseigenen Labor innerhalb weniger Minuten aus einem Tropfen Kapillarblut bestimmen können.
Eine Hals-Nasen-Ohrenärztliche Untersuchung in unserer Praxis ist vor allem bei folgenden Infekten oder dem Verdacht darauf sinnvoll:
- Nasennebenhöhleninfekt (Sinusitis) – durch Endoskopie und Ultraschall, ggf. DVT kann mit hoher Sicherheit zwischen einem viralen und bakteriellen Infekt unterschieden werden und damit die Notwendigkeit einer Antibiotikagabe geklärt werden, ansonsten kann mit einer alternativen, oft auch pflanzlichen Therapie die Gesundung erreicht werden
- Mittelohrentzündung – im Erwachsenenalter v.a. sollte hier ein Übergreifen auf das Innenohr mit der Gefahr eines bleibenden Hörverlustes ausgeschlossen werden, respektive eine entsprechende Erweiterung der Therapie eingeleitet werden
- Gehörgangsentzündung/Trommelfellentzündung (Myringitis) – Unterscheidung zwischen bakterieller Infektion und Pilzinfektion (Mykose)
- Infektionen der äußeren Ohrmuschel (z.B. Perichondritis, Erysipel)
- Rachenentzündung oder Mandelentzündung
- Entzündung der Halslymphknoten – Ultraschall zur Diagnostik und zum Ausschluß von Komplikationen, wie z.B. Vereiterung der Lymphknoten. Im Farbduplex-Modus des Ultraschalls kann die Durchblutung des Lymphknotens, das sogenannte Perfusionsmuster, bestimmt werden, was Aufschluss über Akutheit einer Lymphknotenschwellung und Abgrenzung zu bösartigen Veränderungen ermöglicht
- Husten/Bronchitis – hier kann die Ursache auch in den oberen Atemwegen liegen. Eine genaue Diagnostik wird durch Labordiagnostik und Lungenfunktionstestung (Spirometrie) erreicht. Wir bieten hier eine vollständige Diagnostik und Therapie aller Atemwege aus einer Hand
- Weichteilinfektionen im Kopf- und Halsbereich
- Speicheldrüsenentzündungen – Differentialdiagnose zu Speichelsteinen und Tumoren der Speicheldrüsen
- bei unklaren oder fieberhaften Infekten mit Kopf-Halsbeteiligung
HNO-Praxis am Goetheplatz
Dr. Otterstedde & Dr. Sarkar & Prof. Weidauer
Rossmarkt 23
60311 Frankfurt / M.
Tel: 069 / 26 49 50 - 150
Fax: 069 / 26 49 50 - 160
praxis@hno-docs.de
Praxis:










